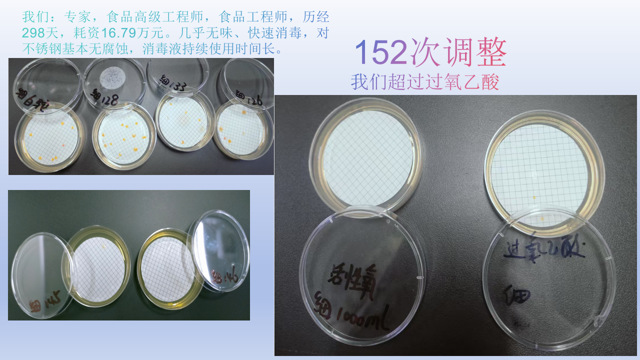
image.png
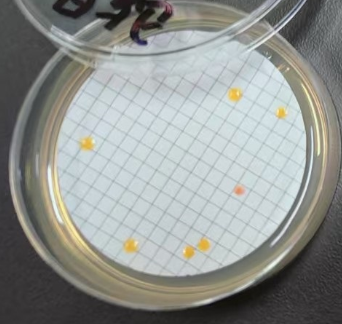
image.png
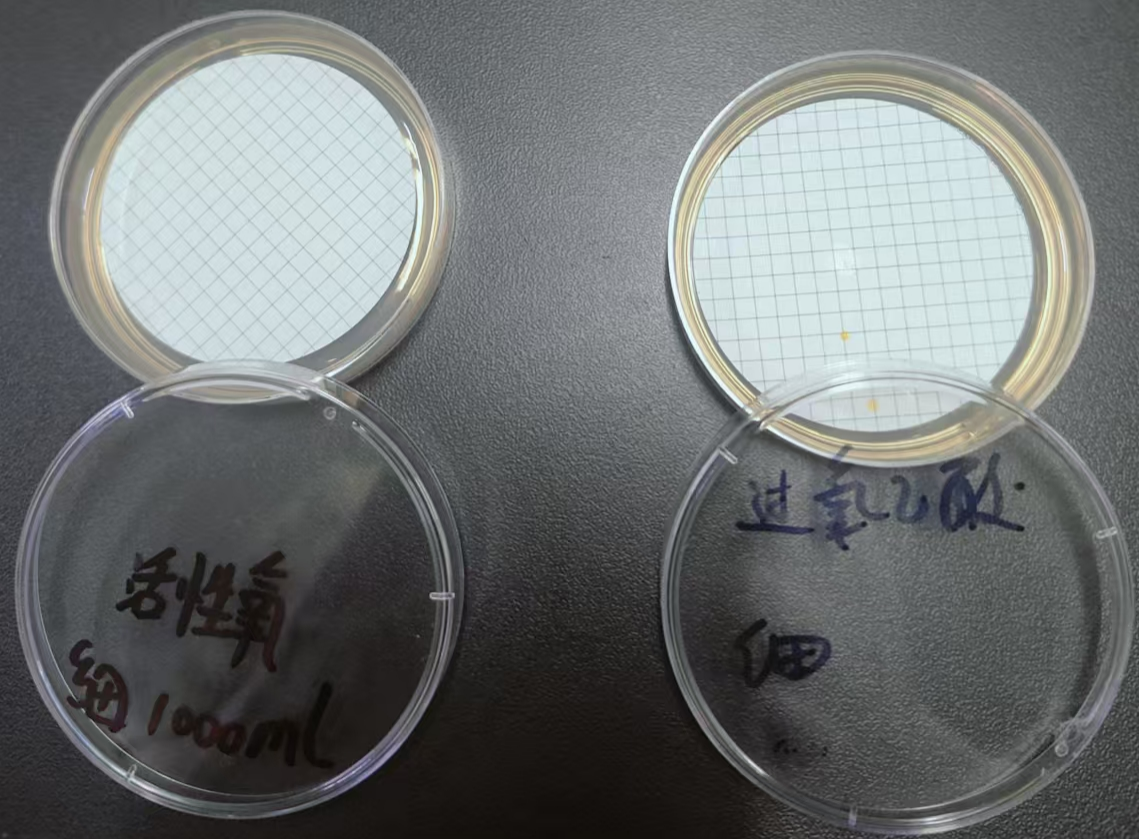
image.png

忠乾牌活性氧消毒粉的五大特点:
一、速溶(冷水也速溶)
二、无气味,且具有消除异味的能力,五倍应用液对皮肤无刺激
三、对不锈钢基本无腐蚀
四、灭菌快速且对数值高(标准溶液30秒杀灭铜绿假单胞菌>99. 999%)
五、具有一定的洗涤效果
忠乾活性氧消毒粉是什么:
一、无明显气味,且能分解异味;
二、30~60秒杀灭铜绿假单胞菌等,广谱性好;
三、对不锈钢基本无腐蚀;
四、五倍应用液:无毒、无致畸突变、无刺激
五、白色粉末,不易结块,冷水快速溶解,不需活化。
忠乾牌活性氧消毒粉是一种以过硫酸氢钾为核心消毒成分的环境友好型消毒制剂,具有广谱杀菌能力,适用于多种场景。可杀灭:大肠杆菌,金色葡萄球菌,白色念珠菌,脊髓灰质炎病毒,铜绿假单胞菌,黑曲霉菌,龟分枝杆菌,枯草杆菌黑色变种芽孢。
忠乾牌活性氧消毒粉原粉属低毒级;5倍应用浓度LD50>5000mg/kg体重,属实际无毒。
忠乾牌活性氧消毒粉原液对小鼠骨髓嗜多染红细胞无致微核作用。
忠乾牌活性氧消毒粉5倍应用浓度进行一次完整皮肤刺激试验,最高皮肤刺激指数为0.00(0~<0.5),刺激强度属于无刺激性。

![]()







忠乾牌活性氧结果:

友商的同类产品的消毒效果:
忠乾牌活性氧和过氧乙酸的消毒效果对比(同样的污水,同样的消毒方式和时间):
忠乾牌活性氧消毒粉不易结块,溶解性好,下面的视频是溶解性测试,不搅拌,直接溶解,不到三分钟完全溶解:
产品质量优良,合作伙伴有:成都全兴矿泉水业有限公司,泸州冰客矿泉水公司,绵阳汇晶鑫,四川巴蜀梦,广安联翔,川西第一泉,什邡红峡谷,四川剑门关矿泉水,成都清友廷,南充沁水水业等。欢迎各界朋友惠顾!
: